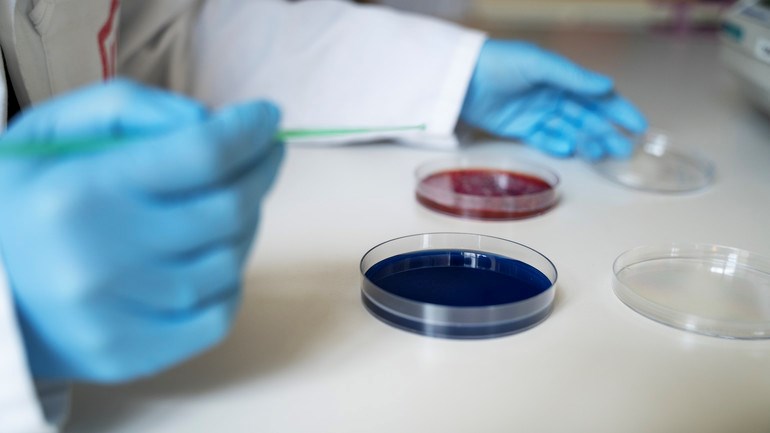

Munbakteriers syratolerans i fokus i ny avhandling
Gabriella Boisens avhandling utforskar munbakteriernas syratolerans, bland annat genom att ha exponerat dem för sjunkande pH-värden och probiotiska bakterier.
Munnen är full av bakterier som skyddar oss från sjukdomar. När vi äter för mycket socker eller slarvar med att borsta tänderna så rubbas bakteriefloran – miljön blir sur. En ny avhandling sätter ljuset på hur munbakterier anpassar sig till sura miljöer.
När bakterier i munnen utvecklar syratolerans så innebär det att de kan överleva i och bidra till en miljö med lågt pH. Och det får i sin tur negativa konsekvenser för munhälsan, eftersom lågt pH bidrar till att utveckla karies.
Gabriella Boisens avhandling utforskar just munbakteriernas syratolerans, bland annat genom att ha exponerat dem för sjunkande pH-värden och probiotiska bakterier.
– Om vi får en bättre förståelse för hur munbakterier utvecklar syratolerans och andra kariesrelaterade egenskaper kan vi också hitta nya sätt att upptäcka och förebygga orala sjukdomar i ett tidigare skede, säger hon.
Bakteriearter kan anpassa sig till sur miljö
Avhandlingsarbetet utgörs av tre delstudier. I den första delstudien analyserade forskarna hur olika munbakterier reagerade på att växa i biofilm och exponeras för gradvis sjunkande pH-värden. Resultaten visade att flera olika bakteriearter kan anpassa sig till en sur miljö och att syratoleransen kan förstärkas när bakterier fäster till en yta eller kommer i kontakt med salivproteiner.
I den andra delstudien tog forskarna plackprover från barn, hälften från barn som var kariesfria och hälften från barn med mycket karies.
– Studien visade att bakterierna från barnen med karies hade högre syratolerans och en annan syraproduktion än bakterierna från de kariesfria barnen, säger Gabriella Boisen.
– Detta visar att plackets egenskaper kan skilja sig åt beroende på individens orala hälsa.
Probiotika förhindrade utveckling av syratolerans
I den tredje och sista delstudien utforskade man om munbakterierna kunde utveckla syratolerans i närvaro av probiotiska bakterier. Resultatet visade att en specifik probiotisk bakterie, Lactobacillus reuteri, förhindrade utveckling av syratolerans hos de orala bakterierna och även förändrade deras genuttryck.
Detta innebär att sådana probiotiska arter skulle kunna påverka de egenskaper hos orala bakterier som bidrar till kariesutveckling.
– Sammantaget så visar avhandlingen att bakteriernas syratolerans kan påverkas av en mängd signaler i deras omgivning. Fortsatt forskning inom det här området skulle därför kunna bidra till nya insikter om både biomarkörer och preventiva åtgärder mot karies.
Om avhandlingen
Gabriella Boisen försvarar sin avhandling den 22 november vid Odontologiska fakulteten.
Avhandlingen "Environmental Effects on the Acid Tolerance of Oral Biofilms" finns tillgänglig att läsa digitalt.